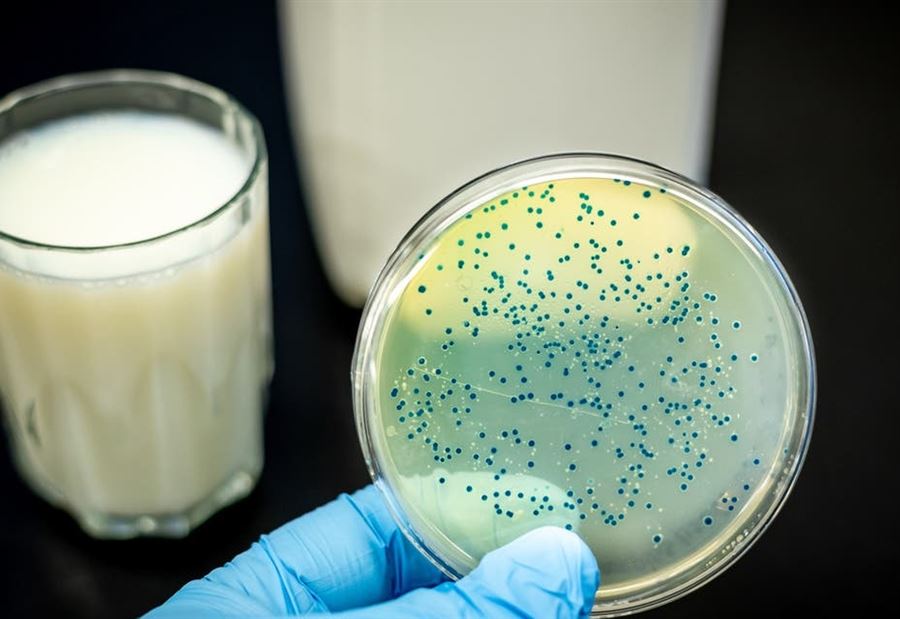

لم تلبث الصين أن تنتهي مما هي فيه، حتى اكتشفت السلطات الصينية إصابة عدة آلاف بمرض بكتيري جديد، إثر تسرب في مصنع تابع لشركة أدوية حيوية في شمال غرب البلاد، وذلك وفقاً لما نقله تقرير لشبكة "سي إن إن" الأميركية.
في التفاصيل، أكدت لجنة الصحة في مدينة لانتشو، عاصمة مقاطعة قانسو، أن 3245 شخصا أصيبوا بمرض البروسيلات الذي غالبا ما يكون سببه ملامسة الماشية التي تحمل البكتيريا.
وذكرت لجنة الصحة بالمدينة أن 1401 شخص آخرين جاءت نتائج فحصهم إيجابية بشكل أولي بالرغم من أنه لم يتم الإبلاغ عن أي وفيات.
كما فحصت السلطات في الإجمال، 21847 شخصا من أصل 2،9 مليون نسمة في المدينة.
ويمكن أن يسبب المرض، المعروف أيضا بإسم حمى مالطا أو حمى البحر الأبيض المتوسط، أعراضا تشمل الصداع وآلام العضلات والحمى والتعب، ويمكن لهذه الأعراض أن تصبح مزمنة.
أما انتقال العدوى من إنسان إلى آخر نادر للغاية، لكن معظم الناس يصابون عن طريق تناول الطعام الملوث أو دخول البكتيريا عن طريق التنفس.
ونتج هذا التفشي عن تسرب في مصنع تشونغمو لانتشو للأدوية البيولوجية حدث بين أواخر تموز، وأواخر آب من العام الماضي.
فقد استخدم المصنع المذكور أثناء إنتاج لقاحات البروسيلا للاستخدام الحيواني، مطهرات منتهية الصلاحية، ما يعني أنه لم يتم القضاء على جميع البكتيريا في غاز النفايات، إلى أن شكل غاز النفايات الملوث الهباء الجوي الذي يحتوي على البكتيريا، وتسرب في الهواء، الذي حملته الرياح إلى معهد لانتشو للأبحاث البيطرية، حيث بدأ التفشي الأول.
وبدأ الناس في المعهد يبلغون عن الإصابة بالعدوى في نوفمبر، وسرعان ما تسارعت الإصابات.
أما بحلول نهاية كانون الأول، فكان ما لا يقل عن 181 شخصا في المعهد قد أصيبوا بداء البروسيلات، وفقا لما ذكرته وكالة أنباء شينخوا الصينية الحكومية.
إلى ذلك، أشار التقرير إلى أن المرض انتقل إلى طلاب وأعضاء هيئة تدريس من جامعة لانتشو، كما انتشر في مقاطعة هيلونغجيانغ في الطرف الشمالي الشرقي للبلاد بعد تسجيل 13 حالة إصابة أخرى.
وفي كانون الأول الماضي، ظهر فيروس كورونا المستجد لأول مرة في الصين وانتشر في جميع أنحاء العالم، إلى أن أودى حتى الآن بحياة 936,095 شخصا على الأقل.
تــابــــع كــل الأخــبـــــار.
إشترك بقناتنا على واتساب

Follow: Lebanon Debate News

الـــمــــزيــــــــــد
الـــمــــزيــــــــــد





